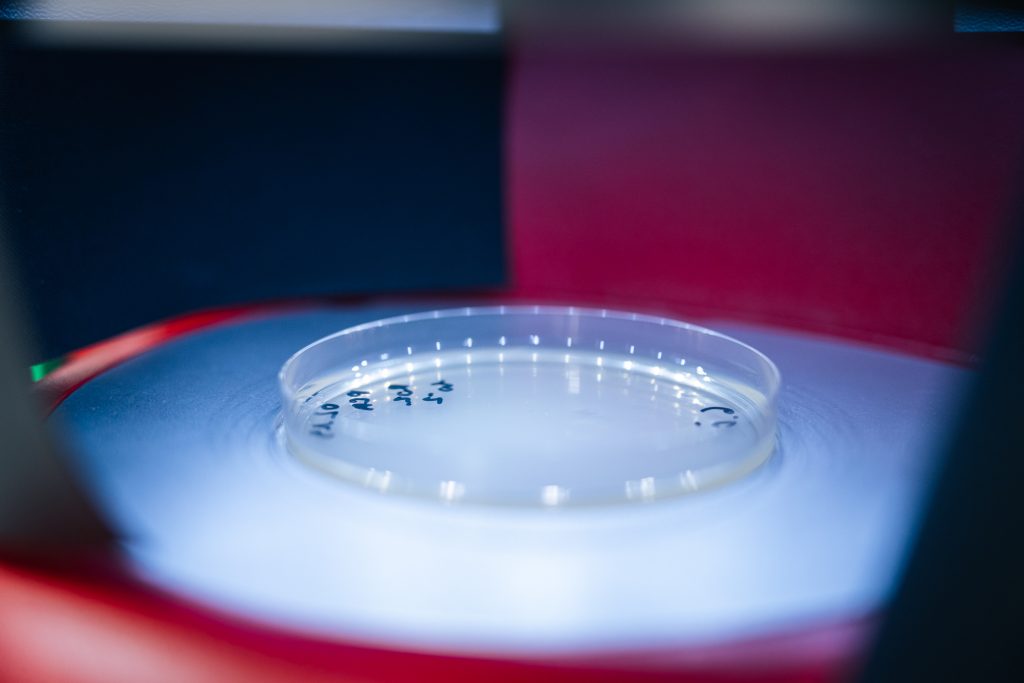

Breakthrough in applied science and innovation at Kauno kolegija: modernised laboratories open new opportunities
Kauno kolegija Higher Education Institution is taking another strategic step to strengthen its position as an institution of applied sciences – modernised laboratories are ushering in a new chapter in the development of applied research, innovation, and study quality.
According to Dr Inga Stravinskienė, Vice Director for Research and Development at Kauno kolegija, the newly equipped laboratories will not only enhance research and experimental development capacity but will also provide opportunities to carry out relevant applied research, train competitive specialists, and develop interdisciplinary solutions that meet regional and national needs. ‘We are delighted that applications for scientific infrastructure funding have been prepared for the Research Council of Lithuania and that financing has been secured for some of the equipment located in these laboratories. This is an investment in a future where innovations emerge from science and knowledge comes from practice.’
From cultural heritage preservation to industrial innovation
The newly opened Materials Physical and Chemical Research Laboratory is equipped with the latest technology, enabling researchers from the Faculties of Arts and Education and Computing, Engineering and Technologies to conduct high-quality applied research and experimental work. Students from the Furniture Engineering, Industrial Design Engineering, and Object Conservation and Restoration programmes will be able to complete laboratory work and develop practical research competencies.
According to Eglė Aleknaitė, a lecturer at the Faculty of Arts and Education, restoration has now gone beyond a traditional craft – it is an interdisciplinary field combining chemistry, physics, materials science, history, art theory and advanced technologies. Modern research infrastructure is therefore essential not only for high-quality applied research but also for practice-based study. ‘This laboratory will make it possible to conduct both non-invasive and invasive analyses – from material composition and structural analysis to determining degradation processes and justifying restoration choices. This is an important step in strengthening Kauno kolegija’s applied research potential and expanding cooperation with museums, archives and libraries.’
Given the limited availability of specialised research infrastructure in Lithuania, E. Aleknaitė notes that this laboratory is significant not only at an institutional level but also regionally and nationally: ‘It will contribute to the consistent development of cultural heritage research and preservation systems.’
Meanwhile, Dr Gintaras Keturakis, Associate Professor and researcher at the Faculty of Computing, Engineering and Technologies, reveals that this laboratory will provide the opportunity to carry out analyses of various materials. It is equipped with a testing machine, a climate chamber, optical microscopes, X-ray diffraction (XRD) and FTIR spectroscopy instruments, as well as surface roughness measurement equipment.
‘This technical base enables the investigation of the physical, mechanical and performance properties of wood and its products, plastics, composites, and finishing materials. Researchers working in the laboratory carry out experimental and R&D projects, prepare high-level scientific publications, and contribute to the development of new technological solutions,’ says Dr G. Keturakis.
Microbiology innovations: from safe food to sustainable cosmetics
At the Diagnostic Microbiology Laboratory, opened under the Computing, Engineering and Technologies Faculty, the modern equipment represents a significant step in reinforcing scientific, innovation and business cooperation. According to Associate Professor Dr Jurgita Mikašauskaitė-Tiso, the laboratory includes a Biosafety Level II laminar cabinet, basic microbiology equipment, fermentation apparatus, a climate chamber, an automatic colony counter, an ultrasonic homogeniser, light and fluorescence microscopes, and a UV-Vis spectrophotometer.
‘All this equipment will make it possible to safely conduct necessary microbiological tests of raw materials, food products, cosmetics and other items. The laboratory stands out for its interdisciplinarity – research will be closely integrated with the Genetics Laboratory at the Faculty of Medicine, opening up opportunities to apply molecular methods for microorganism identification, microbiota composition analysis, gene resistance determination, and functional property studies,’ explains Dr J. Mikašauskaitė-Tiso.
This integration allows a shift from traditional microbiological monitoring to comprehensive biological process understanding and innovative solution development. The laboratory will support innovative projects, including solutions based on waste-free technology to produce sustainable bioglues with lignin for composite materials, and the use of fermented raw materials to create novel snacks and cosmetic products.
These initiatives support the implementation of circular economy principles, increase the value of bio-based materials and encourage the creation of high-value products.
Kauno kolegija’s modern applied science and arts infrastructure, together with its professional community, enables the high-quality and advanced conduct of applied scientific and artistic activities. Applied science and arts efforts are aimed at forming innovative solutions and applying them effectively, addressing pressing social and environmental challenges with the latest scientific knowledge.